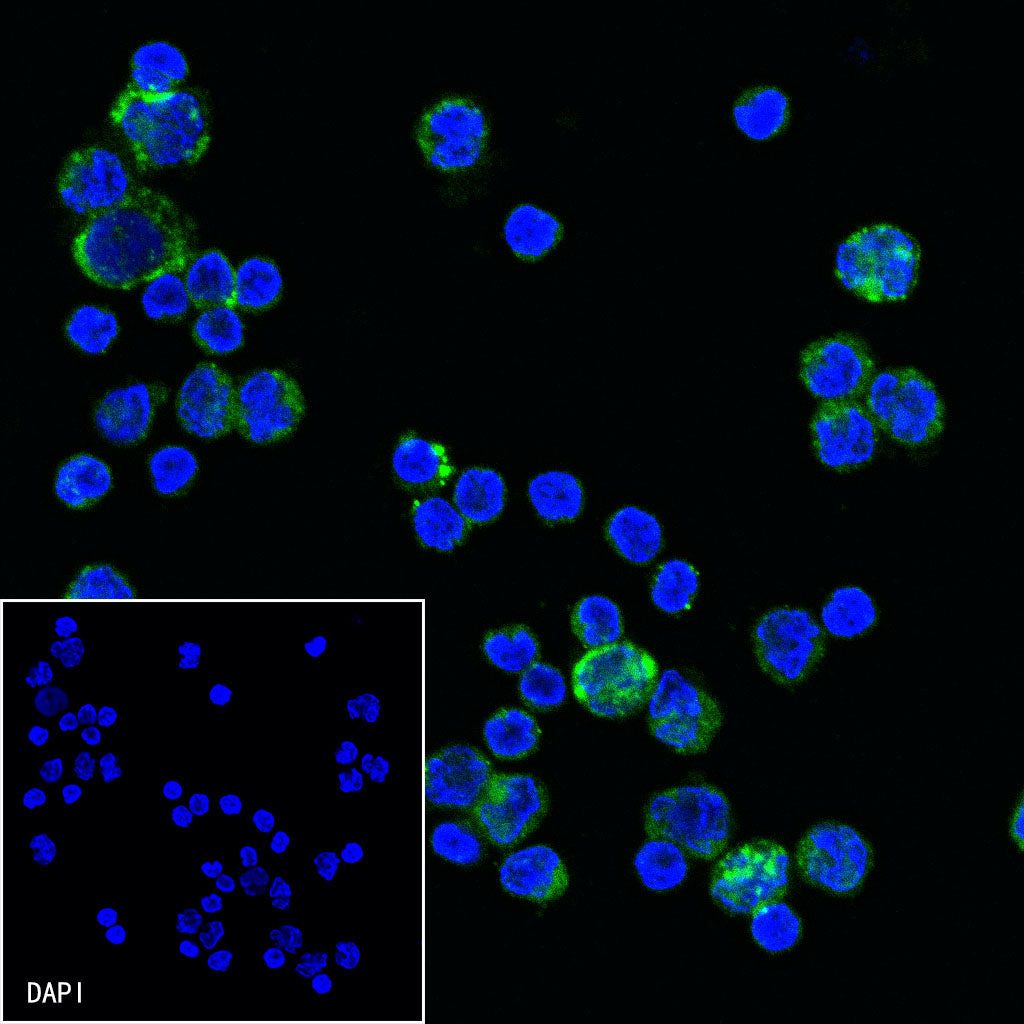

Flow cytometric analysis of human PBMC (human peripheral blood mononuclear cell) labelling CD52 antibody at 1/200 (1 μg) dilution (Right) compared with a Mouse monoclonal IgG isotype control (Left). Goat Anti - Mouse IgG Alexa Fluor® 488 was used as the secondary antibody. Then cells were stained with CD3 - Alexa Fluor® 647 separately. Gated on total viable cells.
Product Details
Product Details
Product Specification
| Host | Mouse |
| Synonyms | CAMPATH-1 antigen, CDw52, Cambridge pathology 1 antigen, Epididymal secretory protein E5, Human epididymis-specific protein 5 (He5), HE5 |
| Location | Cell membrane |
| Accession | P31358 |
| Clone Number | S-R431 |
| Antibody Type | Mouse mAb |
| Isotype | IgG1,k |
| Application | ICC, FCM |
| Reactivity | Hu |
| Purification | Protein G |
| Concentration | 2 mg/ml |
| Conjugation | Unconjugated |
| Physical Appearance | Liquid |
| Storage Buffer | PBS, 40% Glycerol, 0.05% BSA, 0.03% Proclin 300 |
| Stability & Storage | 12 months from date of receipt / reconstitution, -20°C as supplied |
Dilution
| application | dilution | species |
| FCM | 1:200 | null |
| ICC | 1:50 | null |
Background
CD52 protein is a member of an unnamed short-chain GPI-anchored glycoprotein family in humans, which also includes human CD24 antigen and its homologues. CD52 protein is widely distributed and can be found on lymphocytes, monocytes, eosinophils, and dendritic cells derived from monocytes in the hematopoietic system, with a high density of up to 5×10^5 molecules per lymphocyte. In addition, CD52 antigen is also expressed to varying degrees on many lymphocytic malignancies and some acute myeloid leukemia cells. The CD52 protein may also play a role in the transport and targeting of carbohydrates, indicating that it participates in cell processes related to carbohydrate transport.
Picture
Picture
FC
Immunocytochemistry

ICC shows positive staining in human PBMCs. Anti-CD52 antibody was used at 1/50 dilution (Green) and incubated overnight at 4°C. Goat polyclonal Antibody to Mouse IgG - H&L (Alexa Fluor® 488) was used as secondary antibody at 1/1000 dilution. The cells were fixed with 4% PFA and permeabilized with 0.1% PBS-Triton X-100. Nuclei were counterstained with DAPI (Blue).